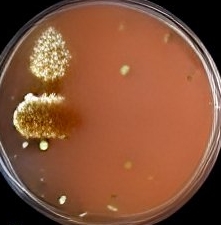
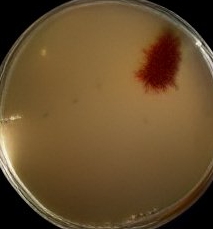

https://rokfin.com/stream/29483

https://rokfin.com/stream/29483

Sharing is Caring, Please donate
- Share on Donations to DSW button (Opens in new window) Donations to DSW button
- Share on LinkedIn (Opens in new window) LinkedIn
- Share on X (Opens in new window) X
- Share on Minds.com (Opens in new window) Minds.com
- Share on Facebook (Opens in new window) Facebook
- Share on Telegram (Opens in new window) Telegram
- Share on Reddit (Opens in new window) Reddit
- Share on Tumblr (Opens in new window) Tumblr
- Email a link to a friend (Opens in new window) Email
- Print (Opens in new window) Print
- Share on Pinterest (Opens in new window) Pinterest
- Share on WhatsApp (Opens in new window) WhatsApp

